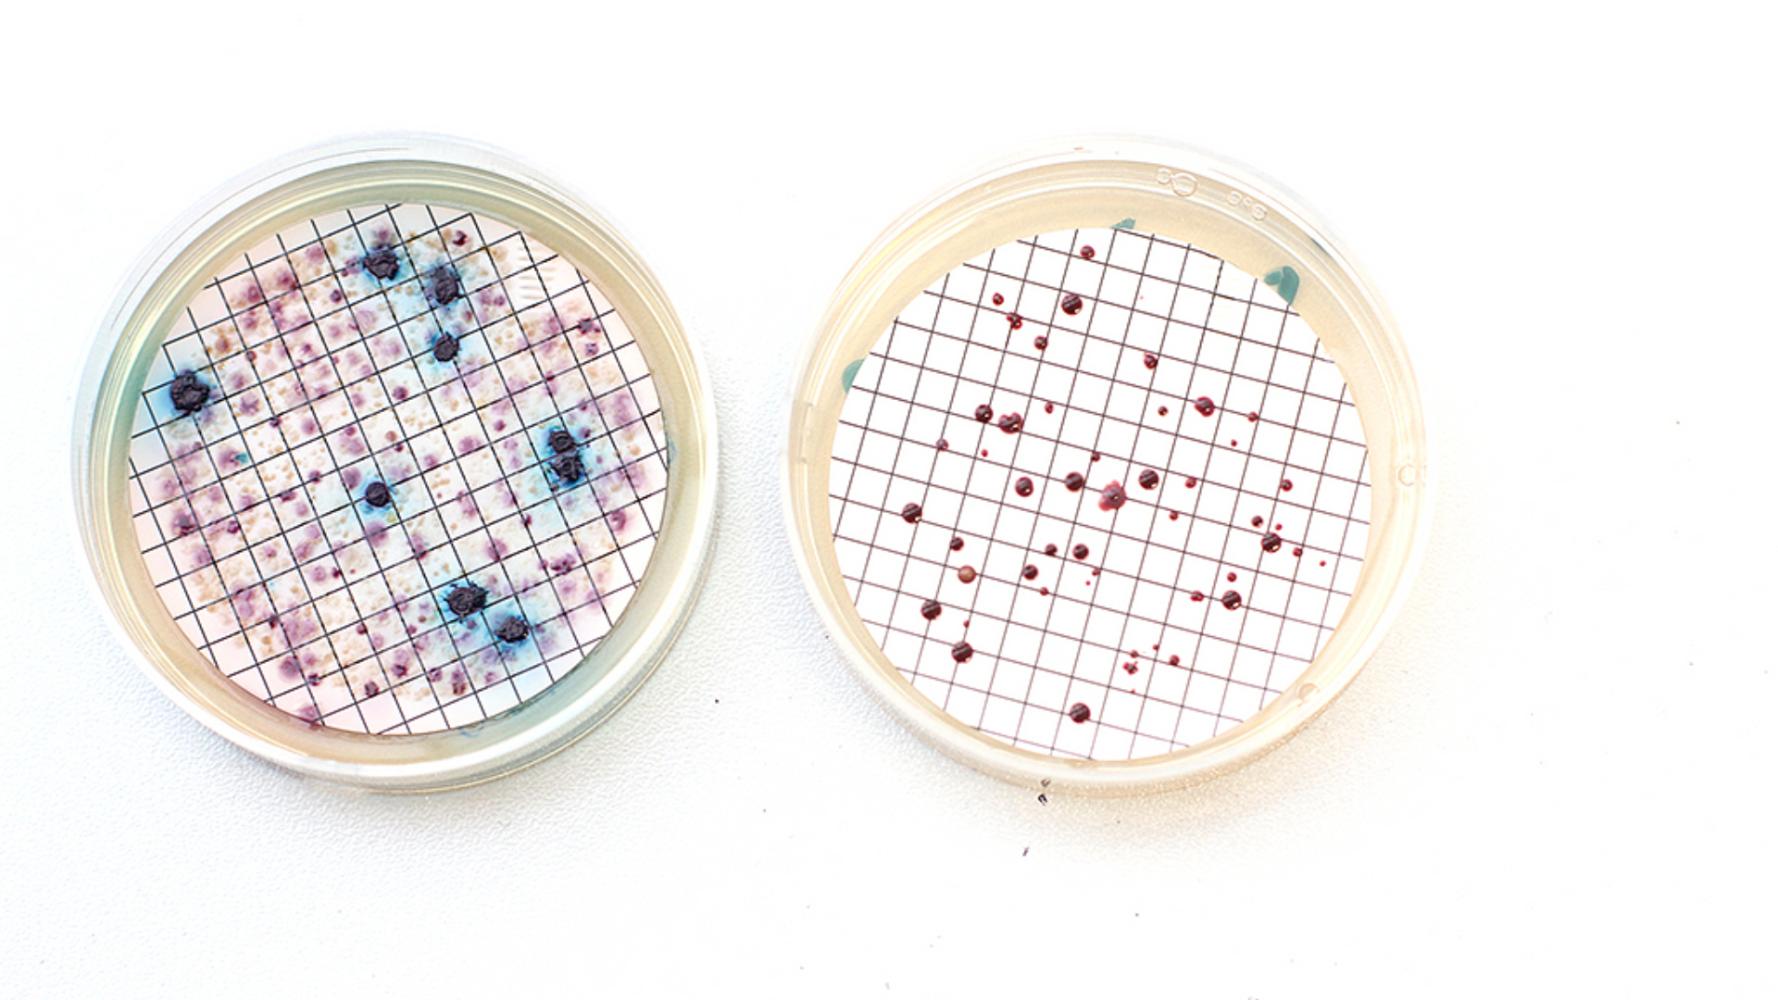

Water analysis within five hours. CXI at TUL receives accreditation for a new pathogen detection method

Until now, water analysis results often took several days. With a new method developed at the Institute for Nanomaterials, Advanced Technologies and Innovation at TUL (CXI), they are available within five hours. That speed can be absolutely crucial when it comes to taking effective measures to protect public health.
The new approach is based on qPCR analysis, which detects and identifies the DNA of pathogenic microorganisms. In the laboratory, there is no need to culture bacteria in nutrient solutions and wait several days for colonies to grow in Petri dishes.
“We are able to obtain results within just a few hours of the sample being delivered. This allows operators of water supply systems to respond almost immediately, for example by adjusting operations, carrying out disinfection or restricting water use before the problem spreads,” explains Magda Nechanická from the Department of Environmental Technologies at the Institute for Nanomaterials, Advanced Technologies and Innovation at TUL (CXI), who developed and validated the new method.
The speed of detection is especially critical for pathogens that can pose a significant health risk, such as Escherichia coli or Legionella pneumophila.
The only facility of its kind in the region and in the country
The rapid molecular genetic analysis based on qPCR is now offered to the public by the Analytical Laboratory of CXI TUL, the only facility of its kind in the Liberec Region. “At our laboratory, clients can have both standard water analyses and modern qPCR testing focused on the rapid detection of pathogens in water or biofilm,” says Lenka Lacinová from the Analytical Laboratory of CXI TUL.
At the same time, CXI TUL is the first facility in the Czech Republic to develop, validate and successfully bring this method to the stage of official accreditation. It is now the only institution in the country capable of analysing a complete range of microbiological organisms in drinking, recreational and hot water.
The future of water monitoring
Another major advantage of molecular genetic methods is that they are not limited to microorganisms that can be cultured in a laboratory. qPCR analysis can also detect pathogens present in biofilms or in forms that conventional methods may overlook, providing a more realistic picture of the actual condition of water systems.
Molecular genetic methods therefore have the potential to become an important part of routine water monitoring. Their use enables faster identification of problems, more effective protection of public health and, overall, greater safety of water resources.
The methodology at CXI was developed with support from the TA CR SIGMA programme and, from the outset, was aimed not only at scientific research but above all at practical application. The technology is now available to water utilities, public health authorities and the wider public, and represents an important step towards modernising water management practice in the Czech Republic.
Recommended articles


Europe Recognises Project from the Liberec Region. Social Robot Robic Wins Professional Community Award